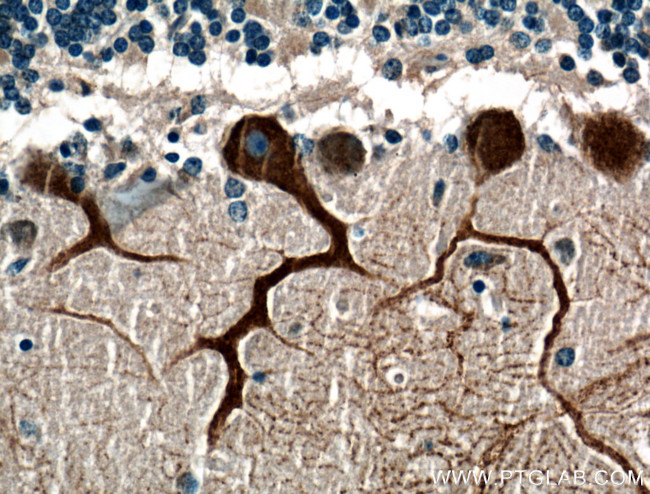
Huntingtin Antibody in Immunohistochemistry (Paraffin) (IHC (P))

Search
Proteintech
Huntingtin Polyclonal Antibody
{{$productOrderCtrl.translations['antibody.pdp.commerceCard.promotion.promotions']}}
{{$productOrderCtrl.translations['antibody.pdp.commerceCard.promotion.viewpromo']}}
{{$productOrderCtrl.translations['antibody.pdp.commerceCard.promotion.promocode']}}: {{promo.promoCode}} {{promo.promoTitle}} {{promo.promoDescription}}. {{$productOrderCtrl.translations['antibody.pdp.commerceCard.promotion.learnmore']}}
产品信息
27206-1-AP
种属反应
宿主/亚型
分类
类型
抗原
偶联物
形式
浓度
规格
纯化类型
保存液
内含物
保存条件
运输条件
产品详细信息
Immunogen sequence: LDVGPEFSA SIIQMCGVML SGSEESTPSI IYHCALRGLE RLLLSEQLSR LDAESLVKLS VDRVNVHSPH RAMAALGLML TCMYTGKEKV SPGRTSDPNP AAPDSESVIV AMERVSVLFD RIRKGFPCEA RVVARILPQF LDDFFPPQDI MNKVIGE (2845-3000 aa encoded by NM_002111)
靶标信息
Huntingtin is a disease gene linked to Huntington's disease (HD), a neurodegenerative disorder characterized by loss of striatal neurons. This is thought to be caused by an expanded, unstable trinucleotide repeat in the huntingtin gene, which translates as a polyglutamine repeat in the protein product. HD is a mid-life onset autosomal dominant neurodegenerative disease that is characterized by psychiatric disorders, dementia, and involuntary movements (chorea), leading to death in 10-20 years.The huntingtin locus is large, spanning 180 kb and consisting of 67 exons. The huntingtin gene is widely expressed and is required for normal development. It is expressed as 2 alternatively polyadenylated forms displaying different relative abundance in various fetal and adult tissues. The larger transcript is approximately 13.7 kb and is expressed predominantly in adult and fetal brain whereas the smaller transcript of approximately 10.3 kb is more widely expressed. The genetic defect leading to Huntington's disease may not necessarily eliminate transcription, but may confer a new property on the mRNA or alter the function of the protein.
仅用于科研。不用于诊断过程。未经明确授权不得转售。
篇参考文献 (0)
生物信息学
蛋白别名: HD protein; HD protein homolog; Huntingtin; Huntington disease gene homolog; Huntington disease protein; huntington disease protein homolog; unnamed protein product
基因别名: AI256365; C430023I11Rik; HD; Hdh; HTT; IT15; LOMARS
UniProt ID: (Human) P42858
Entrez Gene ID: (Human) 3064, (Mouse) 15194